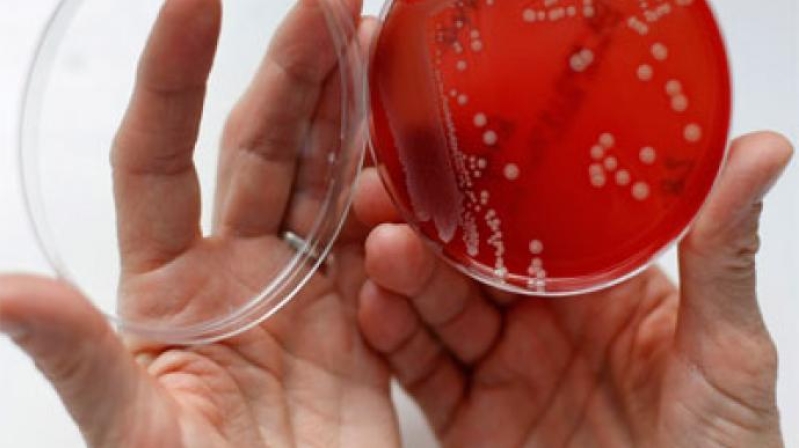
MRSA Superbug

Scientists and doctors have been trying to find antibiotics that would kill the dreaded drug-resistant bacteria known as MRSA. Now a formula dating back to the Middle Ages can kill the modern-day superbug.
According to a report from BBC News, scientists used a formula based on a 9th Century Anglo-Saxon remedy that used onion, garlic and part of a cow's stomach. That remedy, which was intended for use as an eye salve, killed up to 90 percent of methicillin-resistant staphylococcus aureus, otherwise known as MRSA.
"We were absolutely blown away by just how effective the combination of ingredients was," Dr. Freya Harrison said.
Harrison added that the scientific team originally thought the eye salve could show "a small amount of antibiotic activity." According to BBC News, an old English manuscript called Bald's Leechbook contained instructions for making the remedy; that manuscript came from the British Library.
"Anglo-Saxon expert Dr. Christina Lee, from the University of Nottingham, translated the recipe for an 'eye salve,' which includes garlic, onion or leeks, wine and cow bile," BBC News wrote.
According to Sarah Knapton of the Telegraph, the remedy had to be made in a specific manner, which included using a brass vessel in the brewing process, a strainer for purification, and letting the mixture stand for nine days before use. None of the scientists thought that formula would work at all.
"We were genuinely astonished at the results of our experiments in the lab," Lee said. "We believe modern research into disease can benefit from past responses and knowledge, which is largely contained in non-scientific writings."
Knapton reported that the Leechbook is considered one of the earliest known medical textbooks in British culture. According to Lee, the book had "many remedies designed to treat what are clearly bacterial infections, weeping wounds/sores, eye and throat infections, [and] skin conditions such as erysipelas, leprosy and chest infections."
According to Knapton, scientists tested out the formula by making four separate batches with fresh ingredients each time. They compared it with a control treatment that lacked the vegetable compounds.
"None of the individual ingredients alone had any measurable effect, but when combined according to the recipe the MRSA populations were almost totally obliterated," Knapton wrote. "About one bacterial cell in a thousand survived in mice wounds."
Knapton reported that the scientists presented their findings on Monday at the Annual Conference of the Society for General Microbiology in Birmingham. BBC News published a recipe that recreated the salve made by the scientists.
"Equal amounts of garlic and another allium (onion or leek), finely chopped and crushed in a mortar for two minutes," BBC News wrote. "Add 25 ml (0.87 fl. oz.) of English wine - taken from a historic vineyard near Glastonbury. Dissolve bovine salts in distilled water, add and then keep chilled for nine days at 4°C (39.2 °F)."




